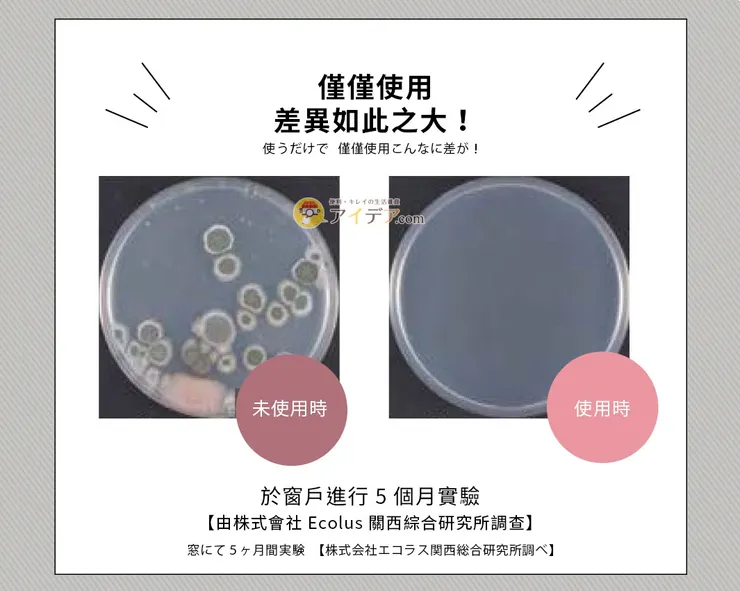
vocus｜新世代的創作平台

你是否有過這樣的經驗?每逢下雨天或換季,打開鞋櫃總有一股悶濕的霉味撲鼻而來,甚至心愛的真皮皮鞋、限量球鞋表面竟然長出了白毛。
鞋櫃因為長期封閉、缺乏通風,是家中最容易滋生黴菌與異味的地方。市售的除臭劑往往只是用強烈香味覆蓋,效果短暫。今天我要分享這款在日本大受好評的 COGIT Power Bio 鞋櫃專用長效除臭防霉貼片盒,它利用微生物力量,讓你徹底告別「臭鞋櫃」。

為什麼這款貼片盒不一樣?(BIO 微生物原理)
不同於傳統的化學除濕包,這款貼片盒的核心是 BIO 微生物(納豆菌屬)。
- 主動出擊: 微生物會釋放酵素,主動分解引起異味的分子(如腳臭來源:異戊酸)。
- 抑制黴菌: 它會與黴菌競爭養分,讓黴菌無法在鞋櫃內生存。
- 安全無毒: 無添加化學藥劑,對於有小孩或寵物的家庭非常友善。
方案對比:為什麼我捨棄了活性碳與除濕包?
在挑選鞋櫃防護產品時,我做了一個簡單的比較,這也是為什麼我最後選擇了 COGIT 貼片盒:
如何正確使用以達到最大效果?
這款產品的使用非常簡單,但有幾個 SEO 小撇步 跟大家分享:
- 貼在最高處: 因為 BIO 微生物是向下擴散的,建議貼在鞋櫃的頂部中央。
- 先清潔再貼上: 貼片是「預防發霉」,如果鞋櫃已有嚴重霉斑,建議先用稀釋酒精擦拭後再貼。
- 搭配日期貼紙: 產品隨附日期貼,寫下日期後貼在盒子上,就不怕忘記更換。
結語:小資族的「被動居家保養」
這款 COGIT 鞋櫃貼片盒 單價雖然比傳統除臭包高一點點,但長達 120 天的效期,換算下來每天不到幾塊錢,就能守護數千元甚至萬元的鞋子免受霉害。
立即查看 COGIT Power Bio 鞋櫃專用貼片盒優惠價格